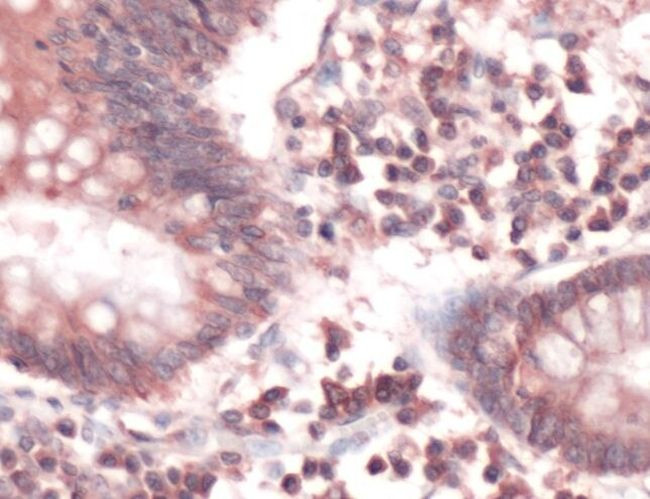
FAS Antibody in Immunohistochemistry (Paraffin) (IHC (P))

Search
Invitrogen
FAS Polyclonal Antibody
{{$productOrderCtrl.translations['antibody.pdp.commerceCard.promotion.promotions']}}
{{$productOrderCtrl.translations['antibody.pdp.commerceCard.promotion.viewpromo']}}
{{$productOrderCtrl.translations['antibody.pdp.commerceCard.promotion.promocode']}}: {{promo.promoCode}} {{promo.promoTitle}} {{promo.promoDescription}}. {{$productOrderCtrl.translations['antibody.pdp.commerceCard.promotion.learnmore']}}

Please note: We are reviewing Western blot images included in the antibody testing data in our catalog, including those provided by third parties. Unless expressly labeled or annotated as “raw-unedited”, Western blot images included in the antibody testing data in our catalog may have been edited, optimized or otherwise adjusted for presentation.
产品信息
PA5-32336
种属反应
宿主/亚型
分类
类型
抗原
偶联物
形式
纯化类型
保存液
内含物
保存条件
运输条件
RRID
产品详细信息
Heat-mediated antigen retrieval is recommended prior to staining, using a 10mM citrate buffer, pH 6.0, for 10 minutes followed by cooling at room temperature for 20 min. Following antigen retrieval, incubate samples with primary antibody for 10 min at room temperature. A suggested positive control is small intestine or colon tissue.
靶标信息
CD95, also known as Fas or APO-1, is a 46 kDa transmembrane glycoprotein that functions as a cell death receptor in the tumor necrosis factor receptor (TNFR) superfamily. It is expressed by a wide range of hematopoietic and non-hematopoietic cells, including monocytes, neutrophils, lymphocytes, and fibroblasts. CD95 also exists in a soluble form weighing approximately 26 kDa. The interaction of CD95 with its ligand, FasL, induces apoptosis, playing a crucial role in peripheral tolerance and anti-viral immune responses. Upon stimulation, CD95 leads to the aggregation of its intracellular Fas-associated death domains (FADD), formation of the death-inducing signaling complex (DISC), and activation of caspases. This cascade results in apoptosis. CD95 is also involved in activating NF-kappaB, MAPK3/ERK1, and MAPK8/JNK, and transduces proliferative signals in normal diploid fibroblasts and T cells. There are at least eight alternatively spliced transcript variants encoding seven distinct isoforms of CD95. Isoforms lacking the transmembrane domain may negatively regulate apoptosis mediated by the full-length isoform. The Fas/Fas ligand system is implicated in several human diseases, including AIDS, hepatitis, and cancer, highlighting its importance in immune regulation and disease pathology.
仅用于科研。不用于诊断过程。未经明确授权不得转售。
篇参考文献 (0)
生物信息学
蛋白别名: Apo-1 antigen; Apo-1 Fas; Apo1 antigen; Apoptosis-mediating surface antigen FAS; CD95; FASLG receptor; OTTHUMP00000020045; OTTHUMP00000020046; OTTHUMP00000020051; OTTHUMP00000059646; Tumor necrosis factor receptor superfamily member 6
基因别名: APT1; FAS; FAS1; TNFRSF6
Entrez Gene ID: (Human) 355